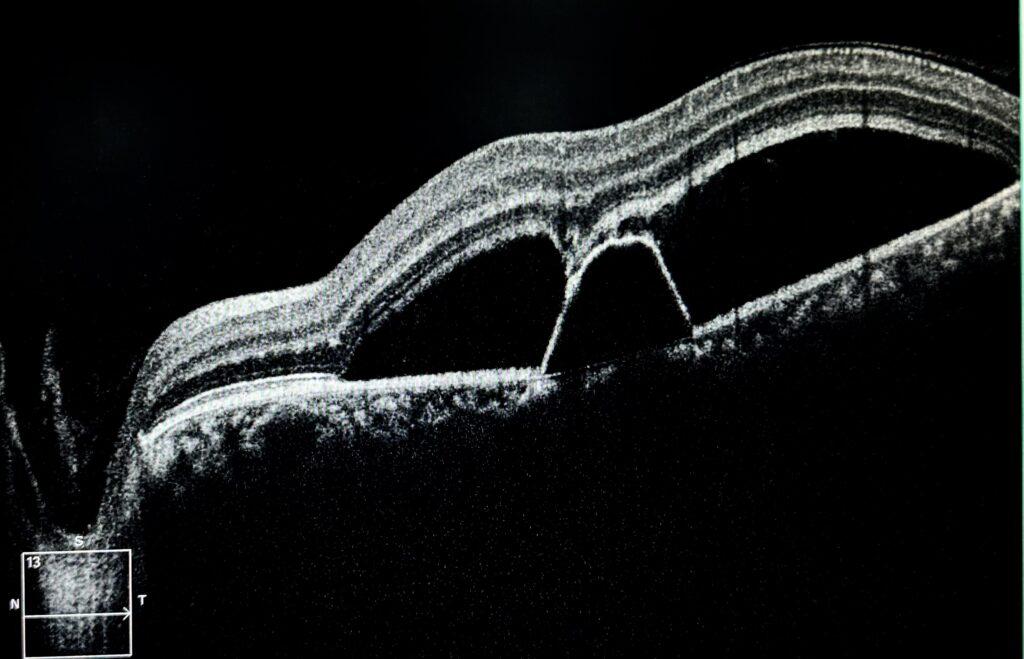

A 23-year-old male patient with central serous chorioretinopathy with large pigment epithelial detachment (PED) and subretinal fluid (SRF) were seen on OCT and was kept on conservative management with lifestyle modification. His vision on presentation was 6/24. On his 1.5 months follow-up examination, his vision had improved to 6/9, and OCT shows regressed PED with no SRF.
Central Serous Chorioretinopathy (CSCR), Central Serous Retinopathy (CSR) or as it has recently been suggested, Pachychoroid Serous Retinopathy (1) (PSR), is an eye condition that causes impaired or blurred vision due to fluid accumulation under the retina, often due to stress and corticosteroid use. Focal attachment of RPE to photoreceptors is a common condition that usually occurs at the leakage site and sometimes the presence of fibrin accompanies. Lifestyle modifications, such as stress management and improving sleep, are crucial in recovery. Conservative management, including observation and avoiding risk factors, is important in the initial period as 50% of cases resolve spontaneously when acute disease first occurs. However, persistent and recurrent cases are also common.

Credit: Aneri Shah Ambani, MD
Affiliation: Core Vision – Eye Clinic, Ahmedabad, India
Instagram Account: @acoupleofeyesurgeons Instagram Personal Account: @aneri.shah.ambani
Caption editing: M. Giray Ersoz, MD, FEBO
Biruni University School of Medicine, Department of Ophthalmology, Istanbul, Turkey
Instagram accounts: @retina.review and @retina.dr.girayersoz
Reference:
- Ersoz MG, Demirel S, Iovino C, Chhablani J, Sarraf D. Is Pachychoroid Serous Retinopathy a Better Name to Describe the Features of Central Serous Chorioretinopathy? Retina. 2024;44(9):1475-1477. doi: 10.1097/IAE.0000000000004215. PMID: 39024659.